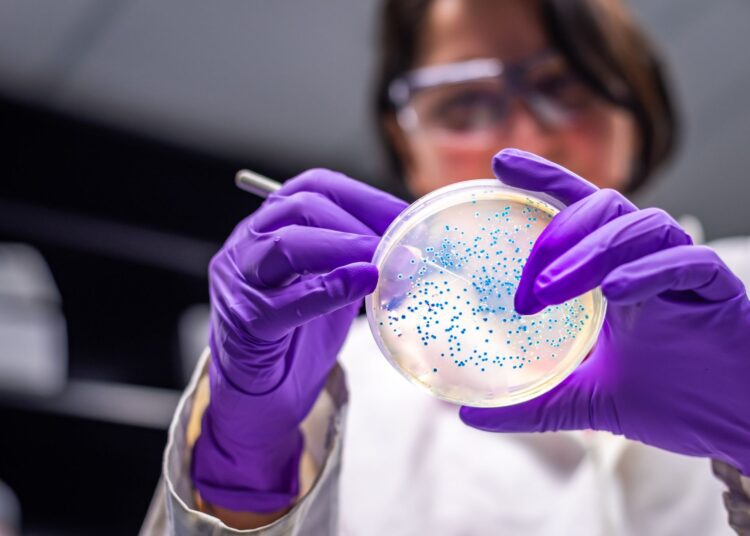

Η ιατρική ακριβείας αποτελεί μία από τις μεγαλύτερες εξελίξεις στη θεραπεία του καρκίνου. Στο επίκεντρο αυτής της προσέγγισης βρίσκονται οι βιοδείκτες, δηλαδή μετρήσιμες βιολογικές ενδείξεις που αντικατοπτρίζουν την παρουσία ή την πορεία μιας νόσου, αλλά και την ανταπόκριση του οργανισμού σε μια θεραπεία. Η αξιοποίησή τους επιτρέπει την προσαρμογή των θεραπειών στις ιδιαίτερες ανάγκες κάθε ασθενούς, επιτυγχάνοντας καλύτερα αποτελέσματα
Τι είναι οι βιοδείκτες;
Οι βιοδείκτες μπορεί να είναι γενετικοί, πρωτεϊνικοί ή κυτταρικοί δείκτες, που ανιχνεύονται σε βιολογικά δείγματα όπως αίμα, ιστός ή σωματικά υγρά. Για παράδειγμα, η παρουσία συγκεκριμένων γονιδιακών μεταλλάξεων (όπως στο γονίδιο EGFR στον καρκίνο του πνεύμονα) μπορεί να καθοδηγήσει τους γιατρούς στην επιλογή στοχευμένων φαρμάκων που αναστέλλουν τη δράση της μετάλλαξης.
Ο ρόλος τους στην εξατομίκευση
Η χρήση βιοδεικτών επιτρέπει:
- Ακριβέστερη διάγνωση: βοηθούν στον καθορισμό του τύπου και της επιθετικότητας του όγκου.
- Καθοδήγηση θεραπείας: δίνουν πληροφορίες για το ποιοι ασθενείς είναι πιθανότερο να ωφεληθούν από συγκεκριμένες θεραπείες (π.χ. ανοσοθεραπεία μέσω έκφρασης PD-L1).
- Παρακολούθηση ανταπόκρισης: μετρώντας τα επίπεδα συγκεκριμένων δεικτών, οι γιατροί μπορούν να αξιολογήσουν αν η θεραπεία λειτουργεί ή αν απαιτείται αλλαγή.
- Πρόγνωση: ορισμένοι βιοδείκτες δείχνουν την πιθανότητα υποτροπής ή εξέλιξης της νόσου.
Οφέλη για τον ασθενή
Η αξιοποίηση των βιοδεικτών συμβάλλει σε πιο στοχευμένες θεραπείες, μειώνοντας τις ανεπιθύμητες ενέργειες που προκύπτουν από γενικευμένα σχήματα. Παράλληλα, αποφεύγονται άσκοπες θεραπείες που δεν θα είχαν αποτέλεσμα, γεγονός που μειώνει και το οικονομικό κόστος. Η προσέγγιση αυτή προάγει μια πιο ανθρώπινη και αποδοτική φροντίδα, εστιάζοντας στη μοναδικότητα κάθε ασθενούς.
Προκλήσεις και προοπτικές
Παρά τα σημαντικά οφέλη, υπάρχουν ακόμη προκλήσεις. Η πρόσβαση σε εξειδικευμένα τεστ μπορεί να είναι περιορισμένη, ενώ η ερμηνεία των αποτελεσμάτων απαιτεί υψηλή επιστημονική εξειδίκευση. Ωστόσο, η συνεχής πρόοδος στη μοριακή βιολογία και στη βιοπληροφορική υπόσχεται ακόμη μεγαλύτερη ακρίβεια στην πρόγνωση και θεραπεία του καρκίνου στο μέλλον.
Πηγή: NHS